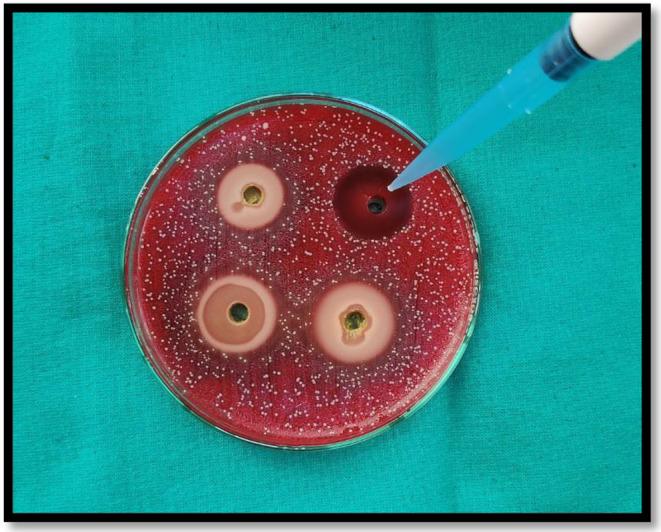
https://cdn.ncbi.nlm.nih.gov/pmc/blobs/bb24/10867452/7b0d307e64d3/FSN3-12-1006-g001.jpg

不同浓度的恰蒂斯加尔邦草药产品-水果提取物抗菌效果的评估与比较:一项体外研究
Evaluation and comparison of antibacterial efficacy of different concentrations of Chhattisgarh herbal product- fruit extract in opposition to : An in vitro study.
作者信息
Doye Shivani Deepak, Malur Manjunath, Sahu Yogesh, Singh Ankita, Mishra Praveen, Mohamed Roshan Noor, Karobari Mohmed Isaqali
机构信息
Department of Conservative Dentistry and Endodontics Maitri College of Dentistry and Research Centre Anjora, Durg Chhattisgarh India.
Department of Pediatric Dentistry, Faculty of Dentistry Taif University Taif Saudi Arabia.
出版信息
Food Sci Nutr. 2023 Nov 29;12(2):1006-1011. doi: 10.1002/fsn3.3814. eCollection 2024 Feb.
Due to the low cost, natural origin, higher safety margins, and little to negligible adverse effects of herbal medications, the use of plants and plant derivatives in medicine is becoming increasingly widespread. is among the most significant medicinal plants in ayurvedic, siddha, unani, and homeopathic remedies. It is ranked first in Ayurvedic material medicine. has been shown to have established effects against various bacterial and fungal infections, including dental caries pathogens. In recent years, there has been a rise in interest in dentistry and medicine related to . The research aimed to assess the antibacterial effectiveness of different concentrations of ethanolic fruit extract (10%, 40%, and 100%) in opposition to and compare it with 2% chlorhexidine. For the study, ethanolic fruit extracts were obtained and prepared with Group I: -10% concentration, Group II: -40% concentration, Group III: -100% concentration, and Group IV: -2% chlorhexidine. Colonies of were cultivated in brain heart infusion (BHI) broth at 37°C and were inoculated in 16 BHI agar plates. Then, on the petri dishes, four wells were created (8 mm diameter) using a metal borer. The Agar well diffusion method was used to examine the antibacterial activity, and the zones of inhibition around the wells were noted. The obtained data were statistically analyzed using one-way ANOVA and post-hoc tests. The result shows that as the concentration increases, there is an increase in the efficacy of the antibacterial property of the extract before it reaches the saturation point. The decreasing order of antibacterial was chlorhexidine >100% >40% >10% . The production of contemporary pharmaceuticals from was addressed, as the global scenario is currently evolving toward using nontoxic plant products with traditional medicinal benefits.
由于草药成本低、源自天然、安全系数高且副作用极小或可忽略不计,植物及其衍生物在医学中的应用越来越广泛。在阿育吠陀、悉达、尤那尼和顺势疗法中,它是最重要的药用植物之一。在阿育吠陀物质医学中排名第一。已证明它对包括龋齿病原体在内的各种细菌和真菌感染有确切疗效。近年来,与它相关的牙科和医学研究兴趣有所增加。该研究旨在评估不同浓度(10%、40%和100%)的其乙醇果实提取物对(某种细菌,原文未明确写出)的抗菌效果,并与2%的氯己定进行比较。在该研究中,获取并制备了其乙醇果实提取物,分为四组:第一组:浓度为10%;第二组:浓度为40%;第三组:浓度为100%;第四组:2%的氯己定。(某种细菌,原文未明确写出)的菌落于37°C在脑心浸液(BHI)肉汤中培养,并接种到16个BHI琼脂平板上。然后,在培养皿上用金属打孔器打出四个孔(直径8毫米)。采用琼脂孔扩散法检测抗菌活性,并记录孔周围的抑菌圈。使用单因素方差分析和事后检验对所得数据进行统计分析。结果表明,在达到饱和点之前,随着浓度的增加,提取物的抗菌性能功效增强。抗菌效果从高到低依次为氯己定>100%的提取物>40%的提取物>10%的提取物。随着全球形势目前正朝着使用具有传统药用益处的无毒植物产品发展,文中探讨了从它生产现代药物的问题。